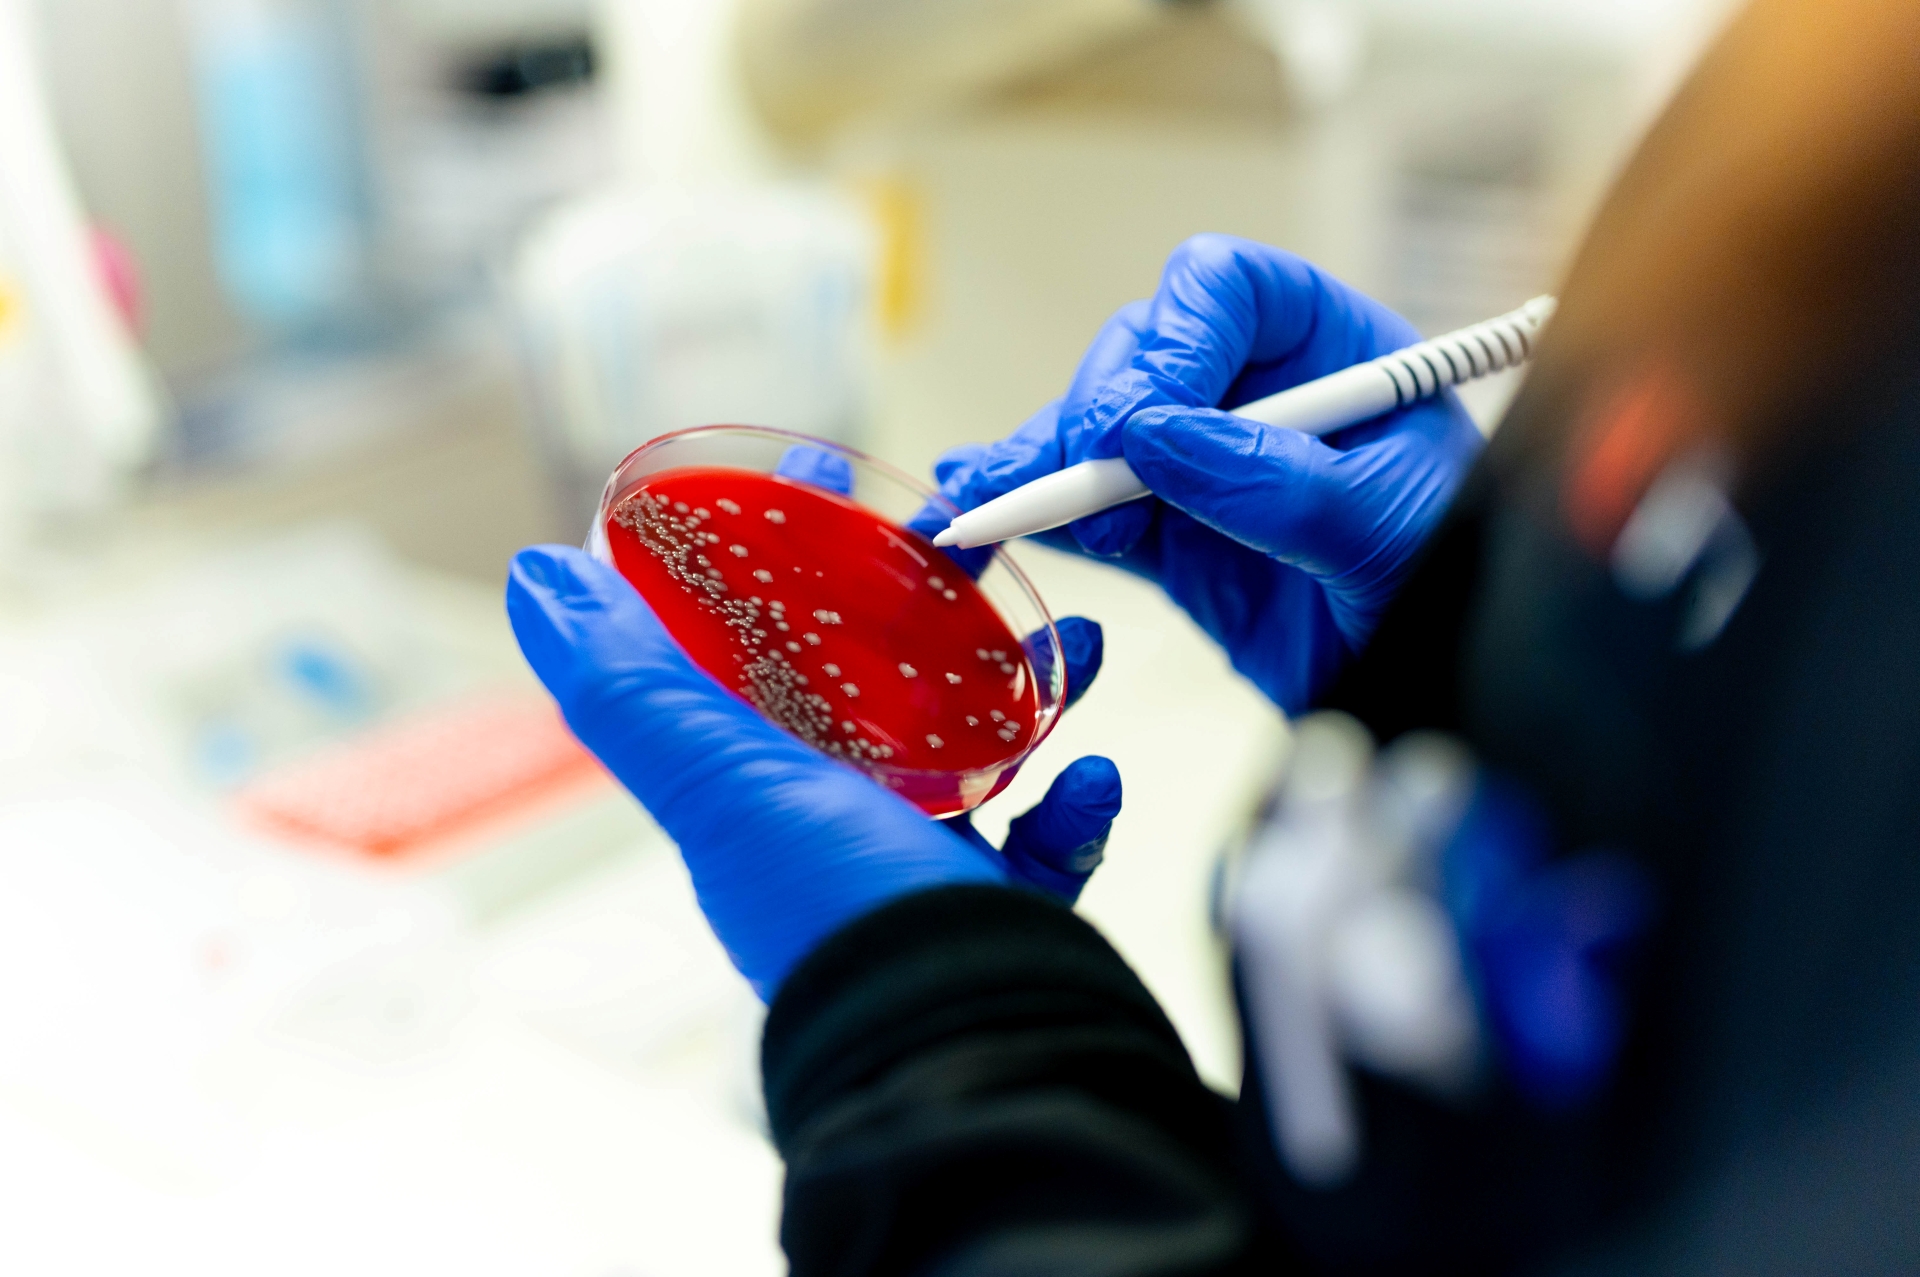

Our clinical pathology laboratory serves patients with complex conditions who need precise testing. Our technologists and subspecialty pathologists provide testing including flow cytometry, lupus panels and electrophoresis. Supporting over three million annual tests across trauma, oncology and outpatient services, we deliver the results needed for expert clinical decisions.
Research and Clinical Trials
Billing and Insurance
Refer a Patient
Research and Clinical Trials
Opportunities to Participate in Trials
Learn about participating in ongoing clinical research supported by the Department of Pathology, contributing to advancements in diagnosis and treatment.
Billing and Insurance
Information on Billing and Insurance Options
Understand billing processes, including insurance coverage details and financial assistance available within UC Health.
Refer a Patient
Refer Patients for UC Health Pathology Services
External and internal physicians can refer cases for review or second opinion with clear instructions on specimen handling and communication pathways.
Research and Clinical Trials
Research and Clinical Trials
Billing and Insurance
Billing and Insurance
Refer a Patient
Refer a Patient
Our Specialties
Our Clinical Pathology Specialties
 Core Laboratory
Core Laboratory
 Microbiology and Molecular Diagnostics
Microbiology and Molecular Diagnostics
Precision Medicine
Precision Medicine
 Toxicology
Toxicology
 Transfusion Medicine and Blood Bank
Transfusion Medicine and Blood Bank

Authoring Breakthroughs
Advancing Diagnostic Excellence With Sophisticated Testing and Expert Care

Clinical Pathology Expertise
Dedicated Team Supporting Complex Patient Care
Our Unique Approach
Patient-First Diagnostic Excellence
Delivering personalized, collaborative clinical pathology and laboratory medicine with expert technologists and subspecialty pathologists. Our team supports complex patients through advanced testing and multidisciplinary teamwork.
3 Million+
Tests performed annually
700+
Bone marrow analyses completed in 2024
1,500+
Flow cytometry diagnostic panels run in 2024
32
Outpatient clinics and two hospitals supported
How to Contribute
Support Advances and Research
Your generous contributions help fuel innovative research, enhance diagnostic services and support education. Every gift strengthens our ability to provide precise, timely testing that improves patient care across UC Health.
Locations
Find a UC Health Lab*
*All lab locations within a Primary Care clinic are closed to the public.
{{location.address.title}}
{{location.title}}
{{selectedLocations[selectedLocations.length - 1].address.title}}
{{selectedLocations[selectedLocations.length - 1].title}}
{{selectedLocations[selectedLocations.length - 1].address.address}} {{selectedLocations[selectedLocations.length - 1].address.address2}}
{{selectedLocations[selectedLocations.length - 1].address.city}}, {{selectedLocations[selectedLocations.length - 1].address.state}} {{ selectedLocations[selectedLocations.length - 1].address.zip}}
{{selectedLocations[selectedLocations.length - 1].hop}}
{{location.address.title}}
{{location.title}}

Contact Us
Contact Us
We're here to help patients, families and referring providers.

